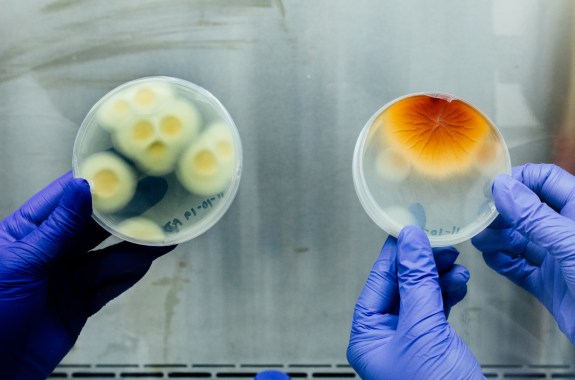
hands holding up two petri dishes, one filled with white and yellow spores and the other with a blooming yellow and orange spore

Lauren J. Young was a digital producer at Science Friday. She crafted and edited pre- and post-show content for ScienceFriday.com so that listeners can get their fill of science stories throughout the week. Among the cool things Lauren has done as a journalist is hold a honeycomb frame filled with bees while standing on the roof of the Waldorf Astoria; cradle a rose hair tarantula in her hands; and re-watch the movies from the Alien franchise to “research” a creepy carnivorous plankton species.
Before joining the SciFri team, Lauren wrote for Atlas Obscura. There, she learned that the Victorians came up with odd inventions for nearly every aspect of daily life and that there are still many wondrous places yet to be explored in the world.
Lauren hails from an ever-growing rodeo town in the San Joaquin Valley of California. She studied biology at California Polytechnic State University, San Luis Obispo. Even though the nearest beach was just a 20-minute drive from campus, she preferred working at the library and cultivating microbes in the lab. She’s got a knack for badminton and continues to help patrons as a library assistant. She’s quite proud of her impressive collection of Pez dispensers and shiny Pokémon.
While receiving her master’s degree in science journalism from NYU, Lauren interned at IEEE Spectrum and Science Friday. She was thrilled to reunite with the team.
A Fever In The Dust
Although still unknown outside of the American West, Valley Fever is a severe fungal infection—and its territory may expand as the climate warms.
25:52
Finding Solutions To Treat Valley Fever
To doctors, valley fever is a medical mystery. And now, the fungal disease is spreading northeast, thanks to climate change.
27:05
Enjoying Spring From Quarantine
Scientists talk about how to glory in the birds, bees, and other joys of spring safely.
16:30
Poetry Wields Science In ‘Unaccountable’ Times
Poet Jane Hirshfield takes on crises both biological and human in her new book “Ledger.”
Your Questions About COVID-19, Answered
You’ve had a lot of questions about the novel coronavirus. We’ve compiled answers and tips from health experts we’ve interviewed on the show.
33:45
Ask A Dentist: Brushing Up On Tooth Science
We talk with dental experts about how your gums affect your heart, frontiers in cavity prevention, and why the future of dentistry is personal.
From Superior To Ontario, Your Love Of The Great Lakes
The Science Friday Book Club rejoiced in memories, thought about water access, and identified invasive species. So, we mapped it.
34:05
A Last Love Letter To The Great Lakes Book Club
The SciFri Book Club wraps its month-long investigation of the Great Lakes with questions about the future of the ecosystems’ recovery.
34:19
How Native American Communities Are Addressing Climate Change
Indigenous tribes are centering climate change management strategies around traditional practices.
Your Cervical Mucus Is Beautiful
The protective substance is an important barrier between the body and the environment. Here’s how researchers are using it to understand health.